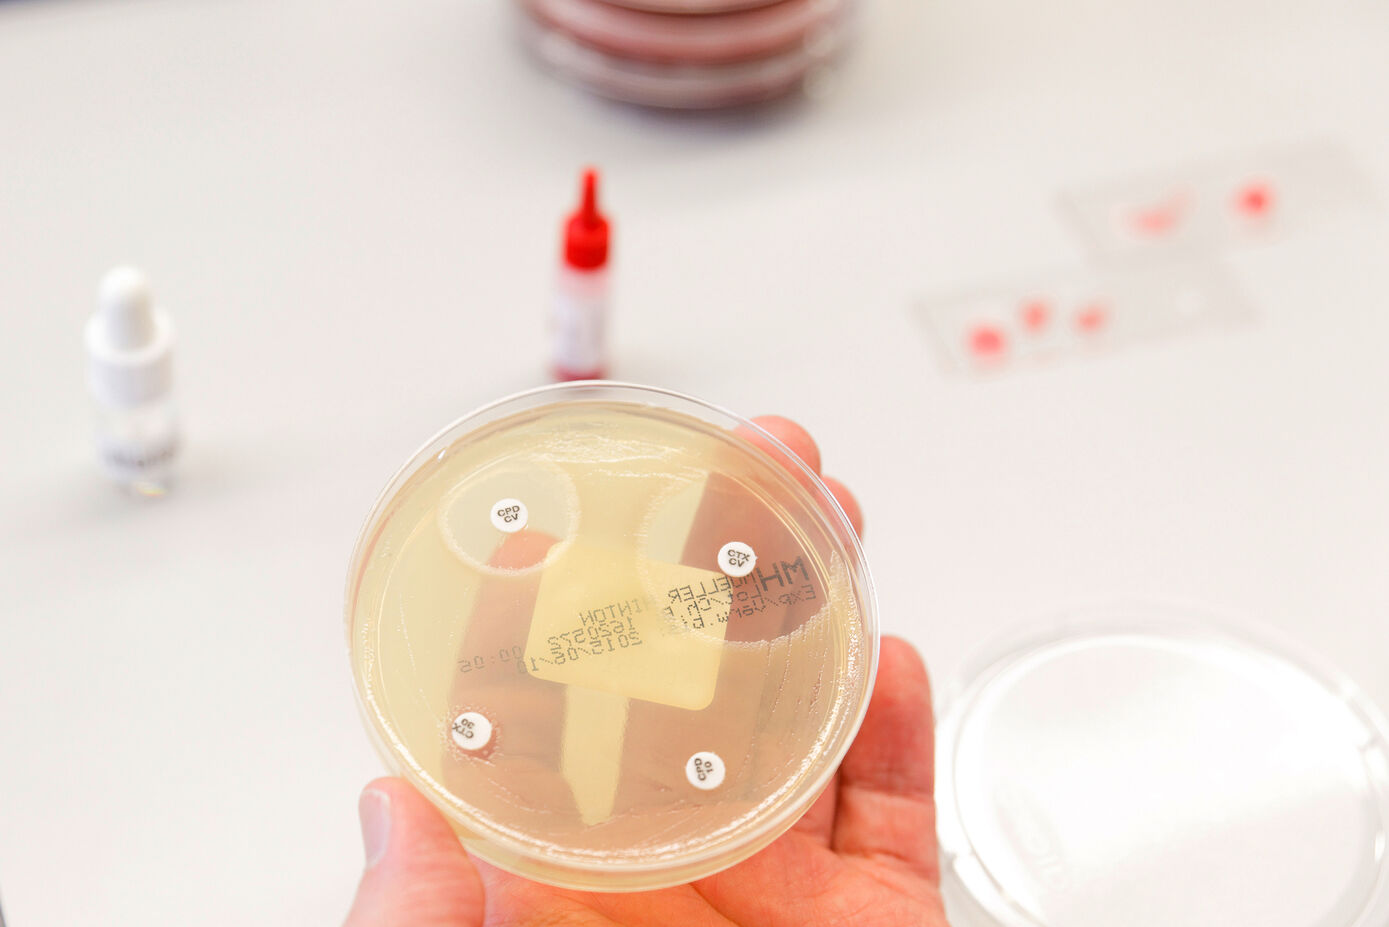
Mikrobiologischer Test auf Antibiotikaresistenzen: Neue S3-Leitlinie für die Behandlung von Infektionen mit multiresistenten Erregern. Fotos: Anna Schroll/UKJ

Jena (UKJ). Seit über zehn Jahren bietet das Institut für Infektionsmedizin und Krankenhaushygiene am Universitätsklinikum Jena für Krankenhäuser in Thüringen und darüber hinaus ein telemedizinisches Konsil an. Diese infektiologische Fachberatung unterstützt behandelnde Ärzteteams bei komplexen diagnostischen und therapeutischen Entscheidungen, insbesondere beim rationalen Einsatz moderner Reserveantibiotika. „Wir müssen sicherstellen, dass neue, hochwirksame Antibiotika gezielt bei den Patientinnen und Patienten eingesetzt werden, die sie aufgrund einer nachgewiesenen Infektion benötigen. Gleichzeitig ist ein restriktiver und präziser Einsatz entscheidend, um ihre Wirksamkeit langfristig zu erhalten und weiterer Resistenzentwicklung entgegenzuwirken,“ erklärt der Direktor des Instituts, der Infektiologe Prof. Dr. Mathias Pletz die zwei zentralen Aspekte.
02.03.2026
UKJ-Erfahrungen in neuer S3-Leitlinie zur Antibiotika-Therapie verankert
Am Uniklinikum Jena etablierte klinische Standards sind jetzt bundesweite Fachempfehlung für die Behandlung von Infektionen mit multiresistenten Erregern

Für einen verantwortungsbewussten Einsatz dieser „sozial-wirksamen“ Medikamente
Die Jenaer Erfahrungen flossen in die jetzt veröffentlichte S3-Leitlinie zur Antibiotikatherapie schwerer Infektionen mit multiresistenten Bakterien ein, die der Bochumer Mikrobiologe Prof. Dr. Sören Gatermann gemeinsam mit Prof. Dr. Mathias Pletz koordinierte. Die Leitlinie erfasst und bewertet den aktuellen Wissensstand und formuliert erstmals für den deutschsprachigen Raum Versorgungsempfehlungen auf dem höchsten Evidenzlevel.
„Jeder Einsatz antimikrobieller Agentien ist verantwortungsbewusst zu gestalten“, betont die Leitliniengruppe, in der federführend die Deutsche Gesellschaft für Hygiene und Mikrobiologie und die Paul-Ehrlich-Gesellschaft für Infektionstherapie sowie zwölf weitere Fachgesellschaften und Patientenorganisationen aus Deutschland und Österreich mitwirkten. Antibiotika seien im Gegensatz zu anderen Arzneimitteln als „sozial-wirksame“ Medikamente zu betrachten, da ihr Einsatz nicht nur Auswirkungen auf einzelne, sondern durch Selektionsdruck und Resistenzverbreitung auf die gesamte Gesellschaft hat.
Weitere Informationen:
- Institut für Infektionsmedizin und Krankenhaushygiene
- S3-Leitlinie Antibiotikatherapie schwerer Infektionen mit multiresistenten Bakterien
Kontakt:
Prof. Dr. Mathias W. Pletz
Institut für Infektionsmedizin und Krankenhaushygiene, Universitätsklinikum Jena


